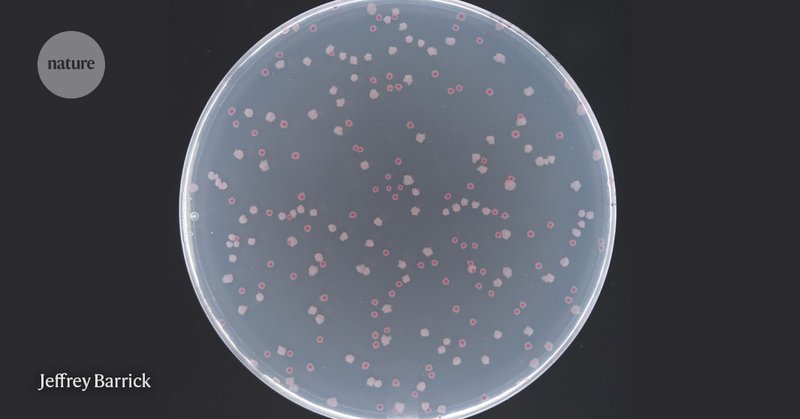
Tweet card summary image

Jeffrey Barrick
@barricklab
Followers
2K
Following
372
Media
51
Statuses
464
We use evolution experiments to understand the genetics of adaptation and engineer microbial evolvability. #synbioevolves #breseq
Austin, TX
Joined November 2014
Thanks for the opportunity to chat about my lab's work and my career path in science! This podcast series is awesome. @ut_mbs @TexasScience @CSSBatUT @BEACON_Center
March is here and Episode 2 of the In Translation podcast is live! In the episode, SPA members @kathryn_brink and @fatimaenam17 interview Professor Jeff Barrick @barricklab from @UTAustin. Check it out! https://t.co/NFRwb7cciN
#engbio
2
1
24
Applications are now open for the 2023 Stengl-Wyer Scholar program at UT Austin. If you are a recent PhD or will graduate soon and have independent ideas for research related to the diversity of life, this is a great opportunity! @mbs @TexasScience
https://t.co/YFHLP6LhSI
cns.utexas.edu
Stengl-Wyer Scholars are postdoctoral scientists in ecology and the life sciences who study at The University of Texas at Austin
0
3
7
#LTEE 77K Update: Detected some hiccups and corrected them. We’re planning to regularly use whole-genome sequencing to monitor the integrity of the populations moving forward. https://t.co/RkX52pUrDN
1
4
41
Help our outstanding @UT_iGEM team send students to present at the #iGEM2023 World Jamboree! https://t.co/d024H7iUGn
@ut_mbs @TexasScience
givecampus.com
0
3
5
Electron Tomography and Machine Learning for Understanding the Highly Ordered Structure of Leafhopper Brochosomes = Great collaborative study led by @DrGabrielBurks @theSchroederLab
pubs.acs.org
Insects known as leafhoppers (Hemiptera: Cicadellidae) produce hierarchically structured nanoparticles known as brochosomes that are exuded and applied to the insect cuticle, thereby providing...
0
4
6
Thanks to Emmanuel Chavarria and all in our lab who have contributed to the #LTEE during the first thousand generations at UT! https://t.co/lfax3DLwL8
@ut_mbs @UTexasILS @TexasScience
0
4
33
#FeaturedProtocol this week: FUGUES (#FUnctionalGenomics Using Engineered #Symbionts); studying the biology of #honeybees utilizing an engineered bee gut bacterium to induce a sustained #RNAi response in the host https://t.co/Gi8ax8RKFM
@barricklab @TexasScience and @spleonard1
0
8
11
🎉Congrats to the @UT_iGEM team for winning the Best Foundational Advance award at the @iGEM Grand Jamboree, for a new rapid test for a deadly disease in bats.🦇 They were also the only top 10 overall undergraduate team from the U.S. https://t.co/7bhXoldMzY
@barricklab @ut_mbs
cns.utexas.edu
Undergraduate students at UT Austin are recognized for their work which could save bats from a condition that is often deadly and dangerous.
0
7
12
Congratulations to the 2022 @UT_iGEM team for winning the the Best Foundational Advance award at the iGEM Grand Jamboree! They were also a top 10 overall undergraduate team, finalists for Best Presentation and Best Part Collection, and awarded a Gold Medal. @ut_mbs @TexasScience
0
8
28
Thanks to Thomas, Flora, Ivan, and everyone else in the TIMC lab for hosting me in Grenoble and sharing so much exciting science. Looking forward to future collaborations and exchanges!
It was wonderful to have Jeff @barricklab in our lab this week. Very fruitful exchanges concerning the in vitro evolution experiment of E.coli over 75000 generations (#LTEE) started by @RELenski. A unique way to understand the mechanisms of genetic and metabolic evolution of bact
0
1
5
Wonderful to see our Glassy-Winged Sharpshooter and brochosome on the cover of @MolBioEvol ! A really fun project with @NancyMoran15 @barricklab @yy_yiyuan_li @vyqtdang Allen Xue, Renee Holmes and Spencer Johnston! Also thanks to our talented artist Jason Zhu for this drawing!
1
11
40
A group of students from @UTAustin are taking part in an international biology competition known as @iGEM. This year, the team of 12 undergrads are trying to protect Austin's beloved bat🦇population. https://t.co/8NsthBGIrP
1
4
12
The UT Austin iGEM team has a fantastic project this year! You can support these students through the 40for40: https://t.co/T7uNmfYo0P; and learn more about their project as they complete their website here in the next couple of weeks: https://t.co/CmJSyKK43j
0
4
9
Fantastic opportunity at UT for independent postdocs. Please spread the word.
Applications for the Stengl-Wyer Scholars program are open! It provides up to three years of support for talented #postdoctoral researchers in the broad area of the diversity of life and/or organisms in their natural environments. https://t.co/bVZIax3wLZ
0
4
8
Congratulations to Kate Elston for defending her PhD thesis on insect symbiont engineering yesterday!
0
2
32
This week Emmanuel Chavarria and Isaac Gifford performed their first #LTEE transfers. Isaac will be coming in to keep the E. coli evolving on the July 4th holiday.
1
1
58
The world’s longest evolution experiment is now in Austin! On Tuesday, Jeff Barrick thawed 12 strains of E. coli that have evolved for 75,000 generations—that’s equivalent to 1.5 million yrs of human evolution. We can’t wait to see what surprises & discoveries are in store! #LTEE
3
17
81
We revived the E. coli #LTEE populations on Tuesday, June 21st, to continue evolving them at UT Austin. 75,000 generations++ Photos and more info in this post. https://t.co/H8bJA4Rl1v
@RELenski
@TexasScience @ut_mbs
5
60
259
As the legendary #LTEE baton is passed on to @barricklab, check out this conversation between @RELenski and @DynamicEcology published in @PLOSBiology back when the LTEE was a mere 27 years (or 60,000 generations) old... https://t.co/vi6YR18WIf
0
24
102
"It should just go on for as long as humanly possible." I had the honour of speaking with @RELenski and @barricklab about making a new home for one of biology's longest running and most important experiments. https://t.co/jMUUNj5Gq2
nature.com
Nature - A laboratory has been growing 12 populations of E. coli since 1988 — this year, the cultures will get a new custodian.
2
81
216
American/Canadian? Like experimental evolution, rodent-pathogen systems, and the desert? My PI Hadas invites excellent researchers to apply for the prestigious Zukerman Fellowship, the fellowship funding my postdoc. I highly recommend it AND the lab! Email: hadashaw@bgu.ac.il
1
11
4